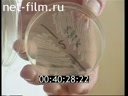
Кадр видео

Фрагмент передачи «Спокойной ночи малыши», ведущая Валентина Леонтьева.
В эти дни этой популярной детской программе исполняется 30 лет.
Сюжет о встрече известных художников Виталия Комара и Александра Меламида.
Они стали авторами картины, которая отобразила художественный вкус нашего народа, полотно написано на основе социологического исследования.
Фрагмент передачи «Взгляд» (июль 1994 г.) о ситуации с «МММ».
Гость в студии: Петр Синицын, кибернетик, специалист системного анализа.
Тема разговора: ситуация с АО «МММ», о путях решения подобных проблем.
О предложениях по развитию рынка и финансовых институтов в стране.
О системном анализе и об участии ученых в решении кризисных проблем.
Сюжет Эдуарда Джафарова из Чечни о напряженной ситуации в республике, связанной с поставкой вооружений оппозиционным силам.
Интервью с Николаем Козицыным, атаманом войска Донского о договоре с чеченским руководством по защите русского населения в республике.
Гость в студии: Матвей Бурлаков, заместитель министра обороны РФ, генерал-полковник.
Бывший командующий западной группой войск.
Тема разговора: вывод войск из Германии.
О расследовании случаев коррупции и воровства.
О решении проблем размещения военнослужащих в местах дислокации.
Сюжет из деревни Сухая Речка, Кунгурского района, пермской области о судьбе Василия Котегова.
Ему 36 лет, из них 18 лет он парализован.
Он сам рассказывает о своем непростом житие-бытие.
О безысходности жизни в российской глубинки.
Гость в студии: Бахыт Килибаев, художник-постановщик рекламного сериала про «МММ».
Тема разговора: творчество и коммерция.
О Сергее Мавроди.
Сюжет Дмитрия Кончаловского из Дагестана о санитарно-эпидемиологической ситуации, связанной с эпидемией холеры.
Об очистных сооружениях.
Говорит главврач Республиканской больницы Шайху Магомедов.
Гость в студии: Сергей Грызунов, заместитель председателя Госкомитета по печати РФ.
Тема разговора: увольнение председателя комитета Миронова.
Защита СМИ от политической цензуры.
Сюжет, в котором художники Виталий Комар и Александр Меламид рассказывают о своей картине, которая отобразила художественный вкус нашего народа и о творчестве, как о процессе.
Синицын Петр
09.09.1994
Чеченская Республика, Чеченская Республика, Чеченская Республика